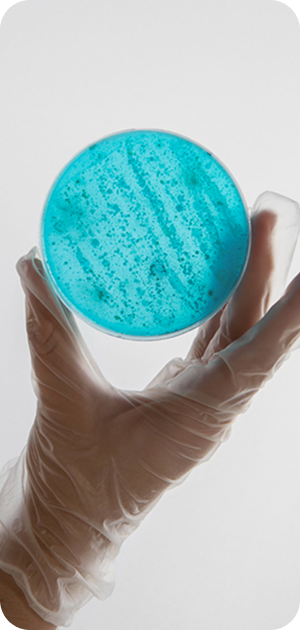
наши услуги

клиника женского и мужского здоровья в Минске

В “Эмбрио” мы верим, что здоровье начинается с доверия, искренней заботы и человеческого участия.

Добро пожаловать в медицинский центр “Эмбрио”
Эмбрио — клиника, которая регулярно внедряет новые современные технологии в медицинскую практику здравоохранения Республики Беларусь. И сегодня мы единственные и первые в стране внедряем искусственный интеллект в эмбриологии.
Мы помогаем тогда, когда другие сдаются. У нас нет «неудобных» случаев — есть лишь уникальные истории, к которым мы подбираем уникальные решения. В клинике «Эмбрио» вы получите не только медицинскую помощь, но и эмоциональную поддержку, искреннюю заботу и реальную возможность стать родителями.
Мы дарим миру новые имена!
«Эмбрио» — первая и единственная клиника в Беларуси, где искусственный интеллект применяется в эмбриологии. Это позволяет ещё точнее выбирать жизнеспособные эмбрионы, повышать эффективность ЭКО и делать путь к родительству короче и безопаснее.
Мы гордимся, что входим в число лидеров репродуктивной медицины страны, и активно внедряем передовые мировые технологии в сферу здравоохранения Беларуси.
Мы объединяем профессионализм врачей, современные методы диагностики и лечения, деликатный подход и высокий уровень медицинского сервиса.
30
лет опыта
Мы гордимся, что входим в число лидеров репродуктивной медицины страны, и активно внедряем передовые мировые технологии в сферу здравоохранения Беларуси.


Каждое направление разработано с учетом новейших международных стандартов , использованием самого современного оборудования и глубокой персонализации подхода
к каждому пациенту.
20 000
новорожденных детей
УСЛУГИ И ТЕХНОЛОГИИ
Центр предлагает полный спектр услуг: от базовой гинекологии до сложных программ вспомогательных репродуктивных технологий (ВРТ). Среди них: ЭКО, ИКСИ, ИМСИ, стимуляция овуляции, восстановление цикла.
НАШ ПОДХОД К ЗАБОТЕ О ВАС
Междисциплинарный подход — у нас врачи разных направлений работают в связке, чтобы найти решение, которое действительно эффективно именно для вас
-
Собственная лаборатория ЭКО
мы контролируем весь путь от обследования до имплантации эмбриона
01 -
Поддержка 24/7
наши пациенты знают, что могут обратиться за советом в любой момент
02 -
Без шаблонов
только индивидуальные программы лечения и ведения беременности
03
Для кого предназначены наши услуги
Эмбрио — клиника, которая регулярно внедряет новые современные технологии в медицинскую практику здравоохранения Республики Беларусь. И сегодня мы единственные и первые в стране внедряем искусственный интеллект в эмбриологии.
-
01
Пар, которые испытывают трудности с зачатием
с любым стажем и диагнозом
-
02
Пар планирующих беременность
от подготовки до индивидуального ведения беременности
-
03
Женщин
нуждающихся в современном и бережном гинекологическом уходе
-
04
Мужчин
с урологическими и андрологическими проблемами
-
05
Пациентов
которым необходимы малоинвазивные или оперативные гинекологические вмешательства
-
06
Тех, кто ищет комплексную диагностику
консервативное и хирургическое лечение от специалистов высокого уровня
Оборудование и лаборатория
Клиника «Эмбрио» оснащена передовыми технологиями в области репродуктивной медицины, хирургии и диагностики. В нашей эмбриологической и диагностической лабораториях — точность и стерильность. Это позволяет нам проводить процедуры максимально точно, эффективно и безопасно, даже в самых сложных клинических случаях.
НАША КОМАНДА
Команда центра — специалисты имеющие международные сертификаты RGI, ESHRE и опыт работы в клиниках США, России, Беларуси, Кипра. Эмбриологи клиники — единственные в РБ, являются сертифицированными клиническими эмбриологами ESHRE (clinical embryologist). Данная сертификация подтверждает высокий профессиональный уровень эмбриолога и признаётся во всех странах Европы и США.
СПЕЦПРЕДЛОЖЕНИЕ
Мы делаем качественную медицину доступнее: скидки на повторное ЭКО, пакеты в рассрочку, банковское кредитование, сертификаты на подарочные обследования. Следите за обновлениями — возможно, именно сегодня ваша мечта станет ближе.
записаться на прием
КОНТАКТЫ
График работы
Трансфер
Маршрутка отправляется каждые 30 минут, начиная с 08:30.
















